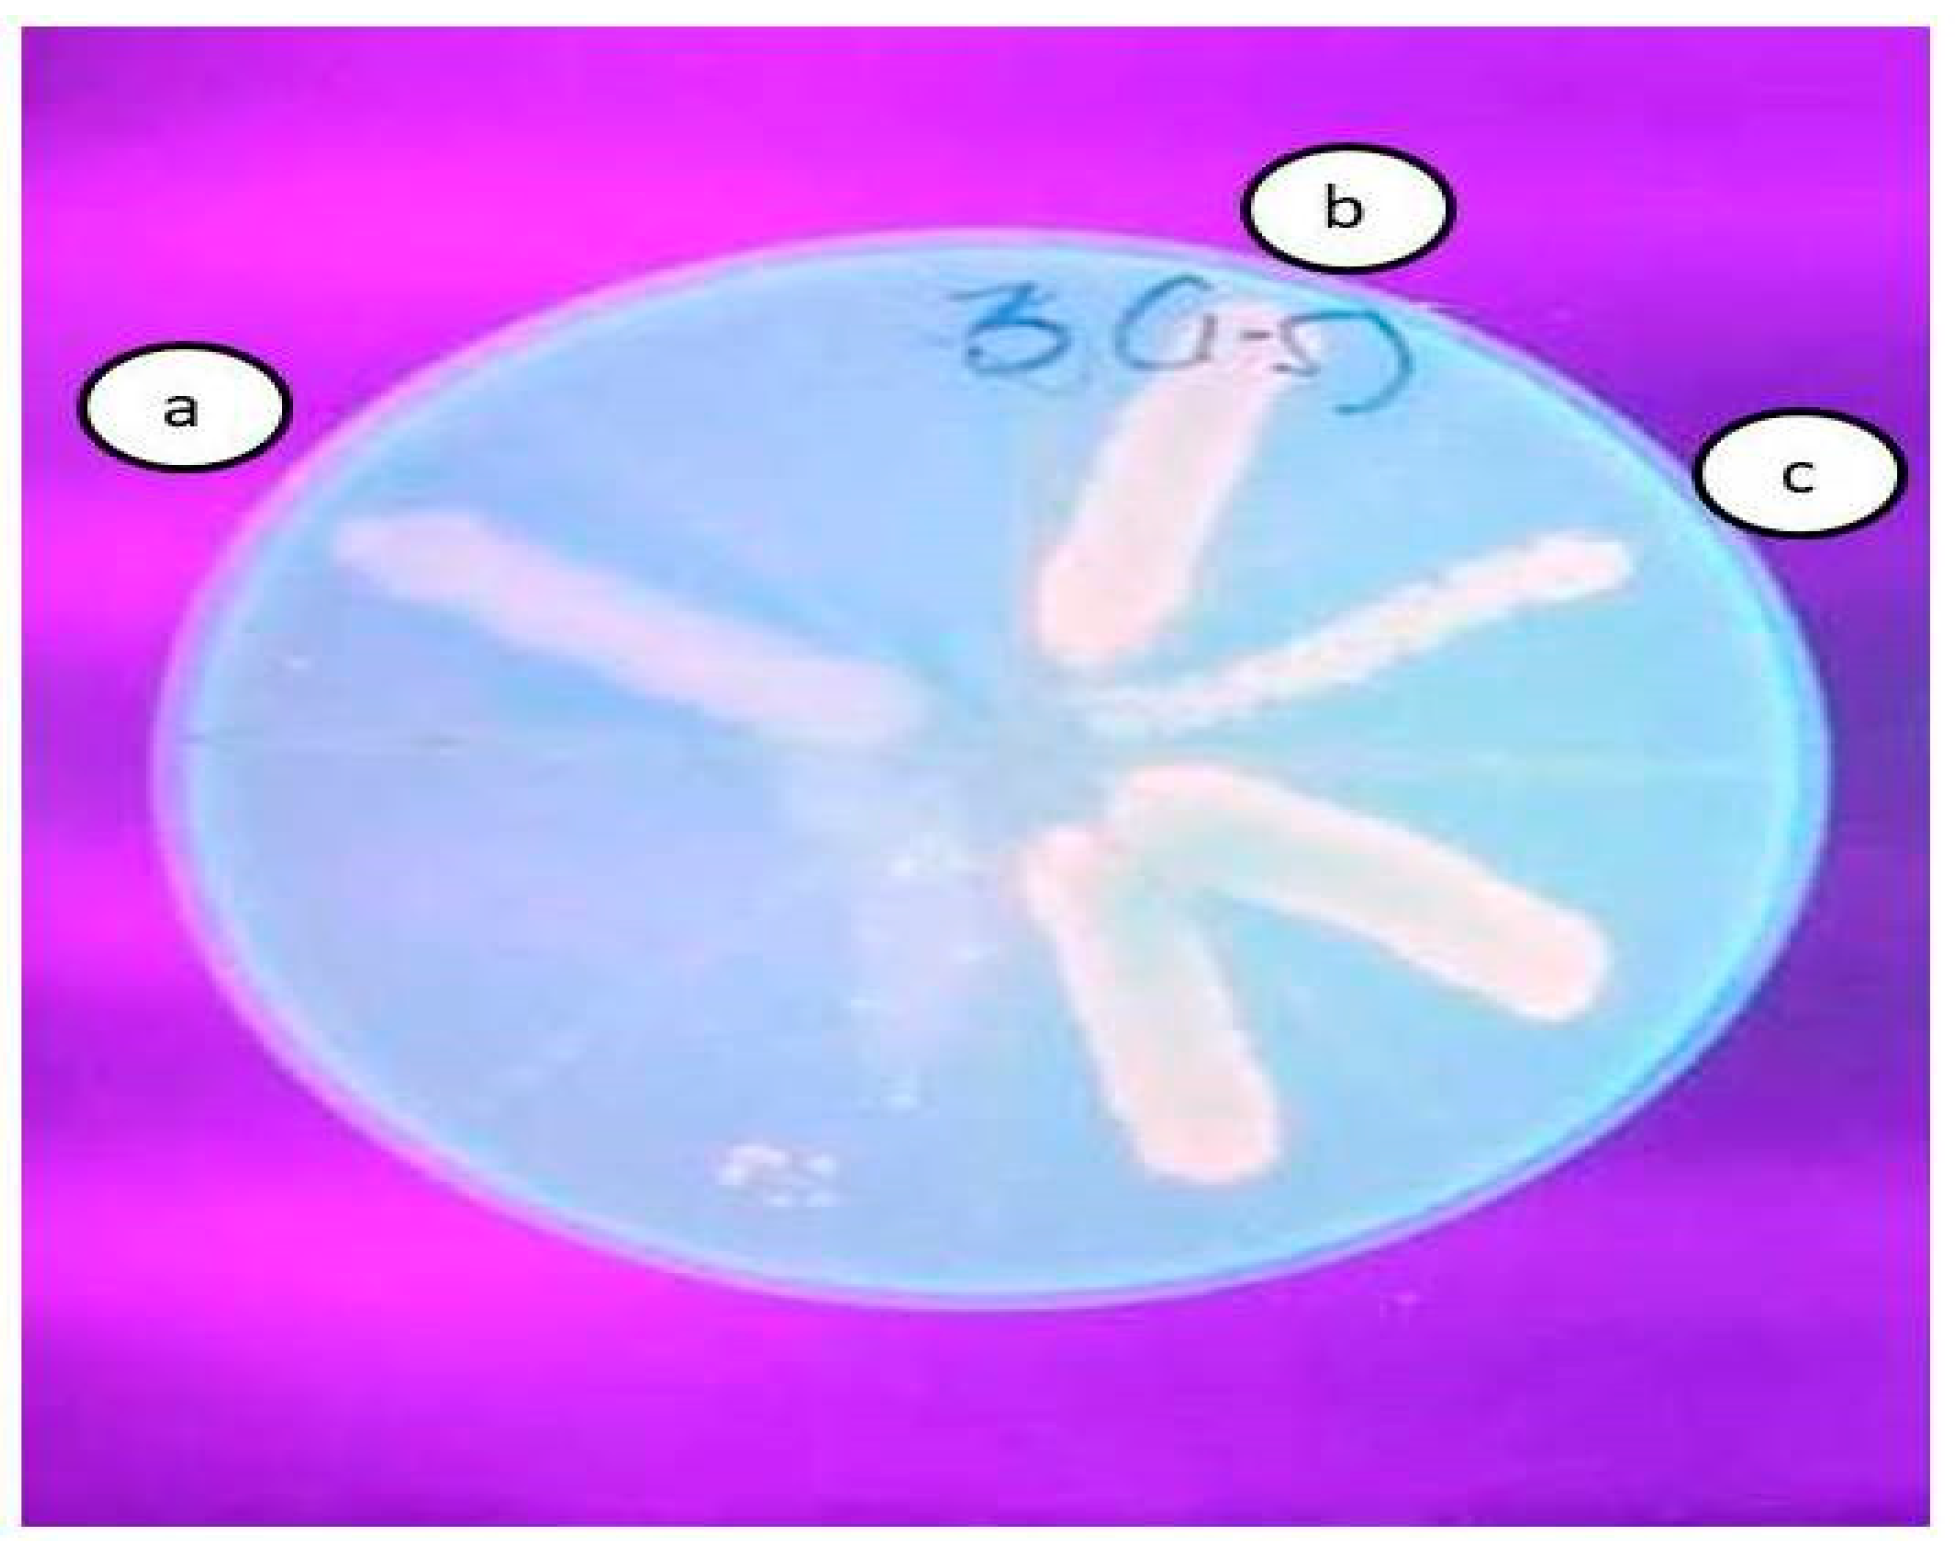

Overexpression of the adeB Efflux Pump Gene in Tigecycline-Resistant Acinetobacter baumannii Clinical Isolates and Its Inhibition by (+)Usnic Acid as an Adjuvant
Abstract
1. Introduction
2. Results
2.1. Bacterial Isolates
2.2. MIC Determination of Tigecycline
2.3. Detection of Efflux Pump Activity Using CCCP as an EPI
2.4. Quantitative Analysis of the adeB Gene in A. baumannii Isolates
2.5. Antibacterial Activity of (+)Usnic Acid against the AI 7574 Isolate
2.6. Checkerboard Synergy Assay
2.7. Ethidium Bromide Agar Cartwheel Test
2.8. qRT-PCR Analysis of Treated and Untreated AI 7574
3. Discussion
4. Experimental Methods
4.1. Sources of Bacterial Isolates
4.2. Chemicals and Reagents
4.3. Determination of Tigecycline Resistance
4.4. Detection of Efflux Pump Activity Using CCCP as an EPI
4.5. Total RNA, cDNA Synthesis, and Real-Time PCR
4.6. Antibacterial Activity of (+)Usnic Acid against AI 7574 A. baumannii
4.7. Checkerboard Assay
4.8. Ethidium Bromide Agar Cartwheel Test
4.9. Expression Analysis of AI 7574 When Treated with (+)UA and Tigecycline
4.10. Statistical Analysis
5. Conclusions
Supplementary Materials
Author Contributions
Funding
Institutional Review Board Statement
Informed Consent Statement
Data Availability Statement
Acknowledgments
Conflicts of Interest
References
- Kyriakidis, I.; Vasileiou, E.; Pana, Z.D.; Tragiannidis, A. Acinetobacter Baumannii Antibiotic Resistance Mechanisms. Pathogens 2021, 10, 373. [Google Scholar] [CrossRef] [PubMed]
- Yadav, S.K.; Bhujel, R.; Hamal, P.; Mishra, S.K.; Sharma, S.; Sherchand, J.B. Burden of multidrug-resistant Acinetobacter baumannii infection in hospitalized patients in a tertiary care hospital of Nepal. Infect. Drug Resist. 2020, 13, 725–732. [Google Scholar] [CrossRef]
- CDC Biggest Threats and Data. Available online: http://www.cdc.gov/drugresistance/biggest-threats.html (accessed on 22 July 2021).
- Ramsamy, Y.; Essack, S.Y.; Sartorius, B.; Patel, M.; Mlisana, K.P. Antibiotic resistance trends of ESKAPE pathogens in Kwazulu-Natal, South Africa: A five-year retrospective analysis. Afr. J. Lab. Med. 2018, 7, 887. [Google Scholar] [CrossRef]
- Pogue, J.M.; Kaye, K.S.; Cohen, D.A.; Marchaim, D. Appropriate antimicrobial therapy in the era of multidrug-resistant human pathogens. Clin. Microbiol. Infect. 2015, 21, 302–312. [Google Scholar] [CrossRef] [PubMed]
- Zhanel, G.; Clark, N.; Lynch, J., III. Infections Due to Acinetobacter baumannii in the ICU: Treatment Options. Semin. Respir. Crit. Care Med. 2017, 38, 311–325. [Google Scholar] [CrossRef] [PubMed]
- Ni, R.T.; Onishi, M.; Mizusawa, M.; Kitagawa, R.; Kishino, T.; Matsubara, F.; Tsuchiya, T.; Kuroda, T.; Ogawa, W. The role of RND-type efflux pumps in multidrug-resistant mutants of Klebsiella pneumoniae. Sci. Rep. 2020, 10, 10876. [Google Scholar] [CrossRef] [PubMed]
- Venter, H.; Mowla, R.; Ohene-Agyei, T.; Ma, S. RND-type drug efflux pumps from Gram-negative bacteria: Molecular mechanism and inhibition. Front. Microbiol. 2015, 6, 377. [Google Scholar] [CrossRef] [PubMed]
- Li, X.-Z.; Plésiat, P.; Nikaido, H. The challenge of efflux-mediated antibiotic resistance in Gram-negative bacteria. Clin. Microbiol. Rev. 2015, 28, 337–418. [Google Scholar] [CrossRef] [PubMed]
- ElKholy, R.; Aladel, R.; Abdalsameea, S.; Badwy, H.; Refat, S. Role of AdeB gene in multidrug-resistance Acinetobacter. Menoufia Med. J. 2020, 33, 205. [Google Scholar] [CrossRef]
- Marchand, I.; Damier-Piolle, L.; Courvalin, P.; Lambert, T. Expression of the RND-type efflux pump AdeABC in Acinetobacter baumannii is regulated by the AdeRS two-component system. Antimicrob. Agents Chemother. 2004, 48, 3298–3304. [Google Scholar] [CrossRef]
- Sugawara, E.; Nikaido, H. Properties of AdeABC and AdeIJK efflux systems of Acinetobacter baumannii compared with those of the AcrAB-TolC system of Escherichia coli. Antimicrob. Agents Chemother. 2014, 58, 7250–7257. [Google Scholar] [CrossRef]
- Coyne, S.; Courvalin, P.; Périchon, B. Efflux-mediated antibiotic resistance in Acinetobacter spp. Antimicrob. Agents Chemother. 2011, 55, 947–953. [Google Scholar] [CrossRef] [PubMed]
- Damier-Piolle, L.; Magnet, S.; Brémont, S.; Lambert, T.; Courvalin, P. AdeIJK, a resistance-nodulation-cell division pump effluxing multiple antibiotics in Acinetobacter baumannii. Antimicrob. Agents Chemother. 2008, 52, 557–562. [Google Scholar] [CrossRef]
- Dal, T.; Aksu, B.; Pagès, J.-M.; Over-Hasdemir, U. Expression of the adeB gene and responsiveness to 1-(1-naphthylmethyl)-piperazine and phenylalanyl-arginyl-β-naphthylamide in clinical isolates of Acinetobacter baumannii. J. Antimicrob. Chemother. 2013, 68, 1200–1202. [Google Scholar] [CrossRef][Green Version]
- Asif, M.; Alvi, I.A.; Rehman, S.U. Insight into Acinetobacter baumannii: Pathogenesis, global resistance, mechanisms of resistance, treatment options, and alternative modalities. Infect. Drug Resist. 2018, 11, 1249–1260. [Google Scholar] [CrossRef] [PubMed]
- Tsioutis, C.; Kritsotakis, E.I.; Karageorgos, S.A.; Stratakou, S.; Psarologakis, C.; Kokkini, S.; Gikas, A. Clinical epidemiology, treatment and prognostic factors of extensively drug-resistant Acinetobacter baumannii ventilator-associated pneumonia in critically ill patients. Int. J. Antimicrob. Agents 2016, 48, 492–497. [Google Scholar] [CrossRef] [PubMed]
- Gupta, M.; Lakhina, K.; Kamath, A.; Vandana, K.E.; Mukhopadhyay, C.; Vidyasagar, S.; Varma, M. Colistin-resistant Acinetobacter baumannii ventilator-associated pneumonia in a tertiary care hospital: An evolving threat. J. Hosp. Infect. 2016, 94, 72–73. [Google Scholar] [CrossRef]
- Peleg, A.Y.; Adams, J.; Paterson, D.L. Tigecycline Efflux as a Mechanism for Nonsusceptibility in Acinetobacter baumannii. Antimicrob. Agents Chemother. 2007, 51, 2065–2069. [Google Scholar] [CrossRef]
- Sinha, S.; Gupta, V.K.; Kumar, P.; Kumar, R.; Joshi, R.; Pal, A.; Darokar, M.P. Usnic acid modifies MRSA drug resistance through down-regulation of proteins involved in peptidoglycan and fatty acid biosynthesis. FEBS Open Bio 2019, 9, 2025–2040. [Google Scholar] [CrossRef] [PubMed]
- Maciąg-Dorszyńska, M.; Węgrzyn, G.; Guzow-Krzemińska, B. Antibacterial activity of lichen secondary metabolite usnic acid is primarily caused by inhibition of RNA and DNA synthesis. FEMS Microbiol. Lett. 2014, 353, 57–62. [Google Scholar] [CrossRef] [PubMed]
- Guo, L.; Shi, Q.; Fang, J.-L.; Mei, N.; Ali, A.A.; Lewis, S.M.; Leakey, J.E.A.; Frankos, V.H. Review of usnic acid and Usnea barbata toxicity. J. Environ. Sci. Health Part C 2008, 26, 317–338. [Google Scholar] [CrossRef] [PubMed]
- Luzina, O.A.; Salakhutdinov, N.F. Usnic acid and its derivatives for pharmaceutical use: A patent review (2000–2017). Expert Opin. Ther. Pat. 2018, 28, 477–491. [Google Scholar] [CrossRef] [PubMed]
- Witt, R.C. The Effects of Selected Lichen Extracts and Purified Compounds on the Rat Heart; University of Nebraska at Omaha: Omaha, NE, USA, 1996; Available online: https://digitalcommons.unomaha.edu/cgi/viewcontent.cgi?article=4385&context=studentwork (accessed on 20 July 2021).
- Marchaim, D.; Pogue, J.M.; Tzuman, O.; Hayakawa, K.; Lephart, P.R.; Salimnia, H.; Painter, T.; Zervos, M.J.; Johnson, L.E.; Perri, M.B.; et al. Major variation in MICs of tigecycline in Gram-negative bacilli as a function of testing method. J. Clin. Microbiol. 2014, 52, 1617–1621. [Google Scholar] [CrossRef] [PubMed]
- Isler, B.; Doi, Y.; Bonomo, R.A.; Paterson, D.L. New Treatment Options against Carbapenem-Resistant Acinetobacter baumannii Infections. Antimicrob. Agents Chemother. 2019, 63. [Google Scholar] [CrossRef] [PubMed]
- Pournaras, S.; Koumaki, V.; Gennimata, V.; Kouskouni, E.; Tsakris, A. In vitro activity of tigecycline against Acinetobacter baumannii: Global epidemiology and resistance mechanisms. Adv. Exp. Med. Biol. 2016, 897, 1–14. [Google Scholar]
- Ardehali, S.H.; Azimi, T.; Fallah, F.; Owrang, M.; Aghamohammadi, N.; Azimi, L. Role of efflux pumps in reduced susceptibility to tigecycline in Acinetobacter baumannii. New Microbes New Infect. 2019, 30, 100547. [Google Scholar] [CrossRef]
- Yang, Y.-S.; Chen, H.-Y.; Hsu, W.-J.; Chou, Y.-C.; Perng, C.-L.; Shang, H.-S.; Hsiao, Y.-T.; Sun, J.-R.; ACTION study group. Overexpression of AdeABC efflux pump associated with tigecycline resistance in clinical Acinetobacter nosocomialis isolates. Clin. Microbiol. Infect. 2019, 25, 512.e1–512.e6. [Google Scholar] [CrossRef]
- JaponiNejad, A.R.; Sofian, M.; Ghaznavi-Rad, E. Molecular detection of AdeABC efflux pump genes in clinical isolates of Acinetobacter baumannii and their contribution in imipenem resistance. ISMJ 2014, 17, 815–823. [Google Scholar]
- Sharma, A.; Gupta, V.K.; Pathania, R. Efflux pump inhibitors for bacterial pathogens: From bench to bedside. Indian J. Med. Res. 2019, 149, 129–145. [Google Scholar]
- Ramis, I.B.; Vianna, J.S.; Reis, A.J.; von Groll, A.; Ramos, D.F.; Viveiros, M.; da Silva, P.E.A. Antimicrobial and efflux inhibitor activity of usnic acid against Mycobacterium abscessus. Planta Med. 2018, 84, 1265–1270. [Google Scholar] [CrossRef] [PubMed]
- Simões, M.; Bennett, R.N.; Rosa, E.A.S. Understanding antimicrobial activities of phytochemicals against multidrug resistant bacteria and biofilms. Nat. Prod. Rep. 2009, 26, 746–757. [Google Scholar] [CrossRef] [PubMed]
- da Costa Júnior, S.D.; da Silva, W.R.C.; da Silva, A.M.C.M.; Maciel, M.A.V.; Cavalcanti, I.M.F. Synergistic effect between usnic acid and polymyxin B against resistant clinical isolates of Pseudomonas aeruginosa. Evid. Based. Complement. Alternat. Med. 2020, 2020, 9852145. [Google Scholar] [CrossRef] [PubMed]
- Dumas, J.-L.; van Delden, C.; Perron, K.; Köhler, T. Analysis of antibiotic resistance gene expression in Pseudomonas aeruginosa by quantitative real-time-PCR. FEMS Microbiol. Lett. 2006, 254, 217–225. [Google Scholar] [CrossRef] [PubMed]
- Araújo, H.D.A.; Silva Júnior, J.G.; Saturnino Oliveira, J.R.; Helena, M.L.; Ribeiro, M.; Barroso Martins, C.M.; Cavalcanti Bezerra, M.A.; Lima Aires, A.; Azevedo Albuquerque, C.P.M.; Melo-Júnior, M.R.; et al. Usnic acid potassium salt: Evaluation of the acute toxicity and antinociceptive effect in Murine model. Molecules 2019, 24, 2042. [Google Scholar] [CrossRef]
- Lu, W.-J.; Lin, H.-J.; Hsu, P.-H.; Lin, H.-T.V. Determination of Drug Efflux Pump Efficiency in Drug-Resistant Bacteria Using MALDI-TOF MS. Antibiotics 2020, 9, 639. [Google Scholar] [CrossRef] [PubMed]
- Yin, Y.; Yue, Z.; Zhang, Y.Z.; Li, F.; Zhang, Q. Over expression of AdeABC and AcrAB-TolC efflux systems confers tigecycline resistance in clinical isolates of Acinetobacter baumannii and Klebsiella pneumoniae. Rev. Soc. Bras. Med. Trop. 2016, 49, 165–171. [Google Scholar]
- Lin, M.-F.; Lin, Y.-Y.; Yeh, H.-W.; Lan, C.-Y. Role of the BaeSR two-component system in the regulation of Acinetobacter baumannii adeAB genes and its correlation with tigecycline susceptibility. BMC Microbiol. 2014, 14, 119. [Google Scholar] [CrossRef]
- Magnet, S.; Courvalin, P.; Lambert, T. Resistance-nodulation-cell division-type efflux pump involved in aminoglycoside resistance in Acinetobacter baumannii strain BM4454. Antimicrob. Agents Chemother. 2001, 45, 3375–3380. [Google Scholar] [CrossRef]
- Higgins, P.G.; Wisplinghoff, H.; Stefanik, D.; Seifert, H. Selection of topoisomerase mutations and overexpression of adeB mRNA transcripts during an outbreak of Acinetobacter baumannii. J. Antimicrob. Chemother. 2004, 54, 821–823. [Google Scholar] [CrossRef]
- Arya, S.S.; Sharma, M.M.; Das, R.K.; Rookes, J.; Cahill, D.; Lenka, S.K. Vanillin mediated green synthesis and application of gold nanoparticles for reversal of antimicrobial resistance in Pseudomonas aeruginosa clinical isolates. Heliyon 2019, 5, e02021. [Google Scholar] [CrossRef]

| Sl. No: | Antibiotic | Resistance | Sensitive |
|---|---|---|---|
| 1 | Piperacillin/tazobactum | 53 | 47 |
| 2 | Amikacin | 49 | 51 |
| 3 | Ciprofloxacin | 56 | 44 |
| 4 | Tetracycline | 54 | 46 |
| 5 | Imipenem | 47 | 53 |
| 6 | Meropenem | 50 | 50 |
| 7 | Tigecycline | 42 | 58 |
| 8 | Colistin | 2 | 98 |
| Sl.No. | Isolate | TGC Alone (µg/mL) | TGC + CCCP (µg/mL) | Fold Reduction | Expression of adeB |
|---|---|---|---|---|---|
| 1 | AI 1444 | 32 | 1 | 32 | 0.96 |
| 2 | AI 7574 | 128 | 2 | 64 | 1.03 |
| 3 | AI 8164 | 32 | 1 | 32 | 0.97 |
| 4 | AI 646-2 | 64 | 1 | 64 | 0.99 |
| 5 | AI 2796 | 16 | 16 | 1 | |
| 6 | AI 670 | 8 | 8 | 1 | |
| 7 | AI 7819 | 64 | 64 | 1 | |
| 8 | AI 646-5 | 16 | 2 | 8 | 0.3 |
| 9 | AI 4185 | 8 | 8 | 1 | |
| 10 | AI 829 | 8 | 2 | 4 | 0.2 |
| 11 | AI 6142 | 64 | 2 | 32 | 0.97 |
| 12 | AI 1187 | 16 | 16 | 1 | |
| 13 | AI 2563 | 64 | 64 | 1 | |
| 14 | AI 6044 | 8 | 8 | 1 | |
| 15 | AI 7783 | 16 | 16 | 1 | |
| 16 | AI 6553 | 8 | 2 | 4 | 0.3 |
| 17 | AI 5678 | 8 | 1 | 8 | 0.3 |
| 18 | AI 6538 | 16 | 2 | 8 | 0.57 |
| 19 | AI 8625 | 32 | 32 | 1 | |
| 20 | AI 3990 | 32 | 2 | 16 | 0.81 |
| 21 | AI 3699 | 64 | 64 | 1 | |
| 22 | AI 4727 | 128 | 128 | 1 | |
| 23 | AI 4888 | 8 | 2 | 4 | 0.4 |
| 24 | AI 3074 | 32 | 2 | 16 | 0.63 |
| 25 | AI 3927 | 4 | 4 | 1 | |
| 26 | AI 6960 | 128 | 128 | 1 | |
| 27 | AI 899 | 32 | 1 | 32 | 0.97 |
| 28 | AI 6428 | 16 | 2 | 8 | 0.47 |
| 29 | AI 7703 | 16 | 16 | 1 | |
| 30 | AI 3636 | 64 | 64 | 1 | |
| 31 | AI 6372 | 8 | 8 | 1 | |
| 32 | AI 306 | 32 | 32 | 1 | |
| 33 | AI 2760 | 64 | 1 | 64 | 0.99 |
| 34 | AI 1259 | 16 | 16 | 1 | |
| 35 | AI 8426 | 8 | 8 | 1 | |
| 36 | AI 5096 | 64 | 64 | 1 | |
| 37 | AI 2540 | 16 | 2 | 8 | 0.43 |
| 38 | AI 7496 | 16 | 4 | 4 | 0.36 |
| 39 | AI 5289 | 64 | 2 | 32 | 0.98 |
| 40 | AI 3840 | 32 | 32 | 1 | |
| 41 | AI 2368 | 8 | 8 | 1 | |
| 42 | AI 2218 | 4 | 4 | 1 |
| Drug A | Drug B | Drug A Concentration in Combination | FICA | FICB | FICi (FICA + FICB) | |
|---|---|---|---|---|---|---|
| Drug A (TGC) + Drug B (UA) | 128 | 1024 | 0.666 | 0.005 | 0.0260 | 0.031 |
| Drug A (TGC) + Drug B (CCCP) | 128 | 256 | 1 | 0.00781 | 0.0976 | 0.105 |
Publisher’s Note: MDPI stays neutral with regard to jurisdictional claims in published maps and institutional affiliations. |
© 2021 by the authors. Licensee MDPI, Basel, Switzerland. This article is an open access article distributed under the terms and conditions of the Creative Commons Attribution (CC BY) license (https://creativecommons.org/licenses/by/4.0/).
Share and Cite
Bankan, N.; Koka, F.; Vijayaraghavan, R.; Basireddy, S.R.; Jayaraman, S. Overexpression of the adeB Efflux Pump Gene in Tigecycline-Resistant Acinetobacter baumannii Clinical Isolates and Its Inhibition by (+)Usnic Acid as an Adjuvant. Antibiotics 2021, 10, 1037. https://doi.org/10.3390/antibiotics10091037
Bankan N, Koka F, Vijayaraghavan R, Basireddy SR, Jayaraman S. Overexpression of the adeB Efflux Pump Gene in Tigecycline-Resistant Acinetobacter baumannii Clinical Isolates and Its Inhibition by (+)Usnic Acid as an Adjuvant. Antibiotics. 2021; 10(9):1037. https://doi.org/10.3390/antibiotics10091037
Chicago/Turabian StyleBankan, Nagaraju, Fathimunnisa Koka, Rajagopalan Vijayaraghavan, Sreekanth Reddy Basireddy, and Selvaraj Jayaraman. 2021. "Overexpression of the adeB Efflux Pump Gene in Tigecycline-Resistant Acinetobacter baumannii Clinical Isolates and Its Inhibition by (+)Usnic Acid as an Adjuvant" Antibiotics 10, no. 9: 1037. https://doi.org/10.3390/antibiotics10091037
APA StyleBankan, N., Koka, F., Vijayaraghavan, R., Basireddy, S. R., & Jayaraman, S. (2021). Overexpression of the adeB Efflux Pump Gene in Tigecycline-Resistant Acinetobacter baumannii Clinical Isolates and Its Inhibition by (+)Usnic Acid as an Adjuvant. Antibiotics, 10(9), 1037. https://doi.org/10.3390/antibiotics10091037

